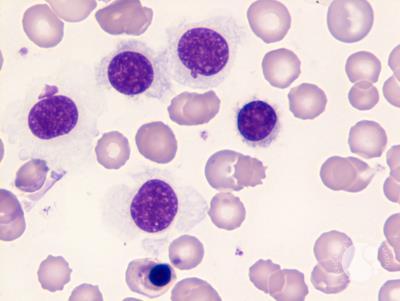
Hairy Cell Leukemia

Dr. R. Srinath Bharadwaj — Best Medical Oncologist in Hyderabad Compassionate Cancer Care
Expert medical oncology treatment with personalized, compassionate cancer care for every patient.
Dr. R. Srinath Bharadwaj
MBBS, MD, DM
Consultant Medical Oncologist, American Oncology Institute, Nallagandla, Hyderabad
-
Evidence-based chemotherapy, targeted & immunotherapy
-
Comprehensive care for solid tumors and blood cancers
-
Personalized treatment planning & follow-ups

About Dr. R. Srinath Bharadwaj
Dr. R. Srinath Bharadwaj is recognized as the best medical oncologist in Hyderabad, providing compassionate, advanced cancer care, chemotherapy, immunotherapy, and targeted therapy.

Dr. R. Srinath Bharadwaj
Consultant Medical Oncologist
MBBS, MD, DM
Education
DM (Medical Oncology and Haematology)
The Gujarat Cancer Research Institute affiliated to B.J Medical College, Ahmedabad
Completed
MD (Radiation Oncology)
MNJIO&RCC affiliated to Osmania Medical College
2017
Internship
Osmania Medical College
2012-13
MBBS
Medical College
2012
Experience
American Oncology Institute
Nallagandla, Hyderabad
Consultant Medical Oncologist (Present)
Apollo Cancer Institutes
Jubilee Hills, Hyderabad
Consultant (2022-2026)
Gujarat Cancer Research Institute
Ahmedabad, Gujarat
DM Resident (2017-2020)
MNJ Institute of Oncology & RCC
Hyderabad, Telangana
MD Resident (2014-2017)
Specializations
Cancer Treatment Services
Comprehensive cancer care services tailored to your needs

Medical Oncology
Comprehensive evaluation and personalized consultation for all types of cancers, focusing on creating an effective, evidence-based treatment roadmap.
Learn More about Medical Oncology
Chemotherapy
Administering state-of-the-art chemotherapy protocols in a comfortable day-care setting, with close monitoring for safety and side-effect management.
Learn More about Chemotherapy
Immunotherapy
Harnessing the power of your own immune system to fight cancer. We provide expert guidance on the latest immunotherapy treatments.
Learn More about Immunotherapy
Hematology
Specialized care for blood disorders and hematologic malignancies including leukemia, lymphoma, and other blood-related cancers with advanced treatment protocols.
Learn More about Hematology
Targeted Therapy
Utilizing precision medicine to target specific cancer cells with tailored drugs, minimizing damage to healthy cells and improving outcomes.
Learn More about Targeted TherapyCancer Treatments Offered
Providing specialized medical oncology care for a wide range of cancers

Lung Cancer

Prostate Cancer

Breast Cancer

Colon Cancer

Liver Cancer

Pancreatic Cancer

Rectal Cancer

Penile Cancer

Testicular Cancer

Adrenal Cancer

Actinic Keratosis

Cholangiocarcinoma

Renal Cell Carcinoma

Gastric Cancer

Malignant Melanoma

Ovarian Cysts

Bone Marrow Cancer
Hairy Cell Leukemia

Acute Lymphoblastic Leukemia

Hodgkin Lymphoma

Langerhans Cell Histiocytosis
Latest Oncology Insights & Articles
Stay informed with our latest insights on cancer care and treatment

Early Detection of Cancer: Signs, Symptoms, and Screening Guidelines
Early detection significantly improves cancer treatment outcomes. Discover the warning signs, recommended screening tests, and when to consult a medical oncologist for evaluation.
Read Article about Early Detection of Cancer: Signs, Symptoms, and Screening Guidelines
Prostate Cancer: Why Early Screening Can Save Lives
Prostate cancer often develops silently. Early screening with PSA and clinical exams can detect it before symptoms appear, allowing simpler and more effective treatment.
Read Article about Prostate Cancer: Why Early Screening Can Save Lives
Managing Chemotherapy Side Effects: A Comprehensive Guide
While chemotherapy is effective, it can cause side effects. This guide covers common side effects, management strategies, and how to maintain quality of life during treatment.
Read Article about Managing Chemotherapy Side Effects: A Comprehensive Guide
Understanding Immunotherapy: A Revolutionary Approach to Cancer Treatment
Immunotherapy has transformed cancer treatment by harnessing the body's immune system to fight cancer cells. Learn about the latest advances and who can benefit from this innovative therapy.
Read Article about Understanding Immunotherapy: A Revolutionary Approach to Cancer TreatmentPatient Testimonials & Success Stories
We are honored to share the experiences of those we have cared for.
" I am Mallika from Vijayawada. I was diagnosed with breast cancer 3rd stage. When first time I met Dr.Srinath Bhardwaj and Dr. Prathima in Appolo hospital, they made me believe that this is only a situation which should be dealt with the help of experts in that area. Dr. Bhardwaj explained target therapy and post effects, with the clear picture of end result. My treatment included 6 chemotherapy sessions, breast removal and reconstruction surgery and 25 sessions of radiation with 17 injections which need to be given every 21 days. Today I am here to THANK my Doctor and whole team, who are literally travelled with me through out my journey. During this period I never felt weak or helpless. They motivated me to lead very much normal life and take rest whenever it is required. Thank you all. "
Mallika
Vijayawada
" Words can't describe how grateful me and my family are towards Dr Bharadwaj sir. He has successfully treated my mother in law who was a stage 3 endometrium carcinoma patient. Today she is cancer free because of the Dr's treatment and humble nature. He responds on WhatsApp so soon to clarify our doubts during treatment. Thank you so much for all that you have done sir. We will forever be indebted to you. I totally recommend Dr Bharadwaj to chemotherapy patients. "
Syeda Sameena
Hyderabad
" My wife was treated (Chemotherapy) for ovary cancer by Dr Bharadwaj, a year back. We came to him as he was highly recommended to us. He is, what a doctor should be: Professionally competent with a human touch. One of the finest doctors that I have come across. He Listened very attentively to us and discussed the line of treatment before administering it. Throughout the treatment, he was always available, even at odd hours, for managing the side effects of chemotherapy. Unlike many other doctors, he is so easy to communicate with. Even after the treatment is over, he is always interested about his patient's wellbeing. We are very happy that we went to him for treatment. Obviously, he is rated 5/5 by us. May he have a long and healthy life!! "
Rakesh Pandey
Hyderabad
Ready to Begin Your Journey?
Schedule a consultation today and take the first step towards personalized, compassionate cancer care.
